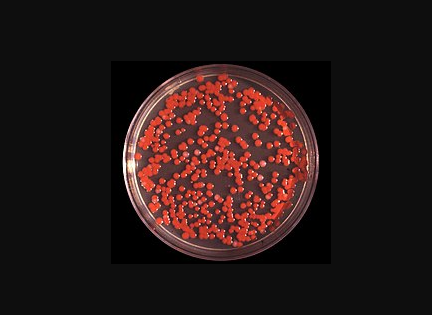
20240606_640_5q416

【加拿大乐活网lahoo.ca 三三综述】 久住大温的华人都喜欢用燃气灶,为的就是燃气灶火力大,能做出热腾腾的“锅气”。然而,最近斯坦福大学的一项研究却显示,温哥华常用燃气灶的苯污染含量在调查的北美17城中最高。

(图片来源:Vancouver is Awesome 2024年6月5日)
先讲一下苯污染是什么哈。苯是一种有毒的有机物,一般在室内装修材料里含量很多,也是一种致癌物。苯污染可以导致白血病和再生障碍性贫血。人体若是吸入过量的苯,就会出现头晕、恶心、胸闷、乏力,严重的时候甚至会出现昏迷,呼吸系统衰竭。慢性苯中毒会对皮肤、眼睛以及上呼吸道系统都有一定的刺激作用。
斯坦福的研究人员在对北美17城的500多个样本进行污染物监测后,发现超97%的样本里都含有苯。
不过,各个城市样本的苯含量差别都很大。来自温哥华样本的苯含量位居第一,比排在二三四名的洛杉矶、卡尔加里和丹佛的苯含量高出一倍,是苯浓度最低的城市波士顿的 50 倍。
波士顿 PSE 健康能源公司的资深科学家兼这项研究的指导作者德鲁·米查诺维茨 (Drew Michanowicz) 表示,由于苯是一种已知的致癌物,因此实际上没有安全的接触水平。理论上来说,苯含量应该是“0”。
米查诺维茨说:“这是我们在天然气中发现的最有毒的化合物。我想说,我们在温哥华发现的苯浓度之高实在有点令人惊讶。”
(17城苯浓度分布图 黑色线为平均值水平 图片来源:Vancouver is Awesome 2024年6月5日)
米查诺维茨表示,过去的研究表明,加州城市的苯含量特别高。温哥华的数字纯属是预期之外,现在研究小组想知道苯含量数字是否也反映了温哥华沿海地区的污染程度。
排放测量科学家戴夫·里斯克 (Dave Risk) 表示,苯浓度的巨大差距可能是因为不同地区的天然气供应来自不同的油田。,数百万年来的地质累积过程意味着BC省东北部和阿尔伯塔省的天然气成分与美国东海岸的天然气成分不同。
这项研究让小编想起了一项困扰医学界多年的难题:为什么很多不吸烟的亚裔女性得肺癌的概率要远远高于其他族裔?

(图片来源:NBC News 2024年3月7日)
根据加利福尼亚州的一项研究,除不吸烟的亚裔美国女性外,其他所有群体的肺癌发病率都在下降——而亚裔美国女性的肺癌发病率实际上每年都在增加 2%。
虽然肺癌传统上与香烟有关,但美国每年有多达 20% 的病例发生在从不吸烟者身上。然而,这一数字在亚裔女性身上却尤其高,对于患有肺癌的华裔和印度裔美国女性来说,不吸烟者的比例上升到 80% 至 90%。
不吸烟还患肺癌?难道这是种族的先天劣势?
近些时日,加州大学和纽约大学进行的研究可能会给医学界一个答案。
加州大学旧金山分校流行病学家斯嘉丽·戈麦斯是一名华裔,7岁那年随父母移居美国,和许多移民家庭一样,在中餐馆工作成为了他们来美国后的第一份工,这也意味着母亲在不断接触着致癌物——炒菜的油烟。
戈麦斯表示,到目前为止,针对亚洲女性非吸烟者的研究已经发现了烹饪油烟、二手烟、空气污染和室内燃煤取暖等致癌风险因素。
然而,最近一项研究发现,亚裔吸入的微小污染颗粒比美国白人多 73%,这也是患癌的可能性之一,而亚裔导致大量可吸入颗粒物的原因只有一项:贫穷。
与白人相比,亚裔居住的地方更多受到建筑、工业和车辆排放的影响。空气污染还可能导致基因变化,使得亚裔患者的致癌表皮生长因子受体突变率最高,这会导致健康细胞不受控制地分裂并长成肿瘤。
放眼到温哥华来说,天然气中的高浓度的苯或许也成为了致癌的影响因素之一吧……
大温红色水垢困扰网友:到底是个啥?!
除了厨房中看不见风险,大温日常生活中还有肉眼可见的风险因素。在大温住了一段时间的朋友估计都难不留意到,浴室、水池、马桶里常常会留下一圈粉红色的水渍。这也让很多网友在社交媒体上发出疑问:这粉色的水渍到底是啥?该怎么解决?
(图片来源:小红书 )
讲真,小编在查阅了一些资料后发现,这事儿说大不大,说小不小。首先,虽然加拿大的自来水号称是直饮级别的,但是在大温等地区,自来水中的铁含量偏高。在浴室等地方用水时,水分后来蒸发了,但水中的铁离子却以氧化铁的形式留在了地漏、瓷砖缝的地方。
氧化铁是红色的,这也就形成了下水管附近粉色的水渍。针对这种情况,使用去垢剂清洗、使用醋或柠檬酸溶液擦拭都能有效去除水渍。如果想省事,装个滤水器更好。
还有一种情况,就稍微严重一些。这种水垢不仅是粉红色的,摸起来还黏黏滑滑的。这可能代表着您的浴室受到了“黏质沙雷氏菌”的入侵。黏质沙雷氏菌(Serratia marcescens ) 又称灵杆菌,这是一种产生鲜红色素的细菌,存在于空气和水中,可生长在动、植物性食品中。
(图片来源:维基百科)
据Yahoo News,美国芝加哥大学微生物学家Jack Gilbert指出,这种细菌可能导致眼部、胸部或者尿路感染,重则有丧命的风险。
具体来说,黏质沙雷菌可以在泌尿道、呼吸道和伤口等多个部位引起感染,有时也会感染眼睛,这将可能导致结膜炎、角膜炎等病症。如果借由呼吸器等导管进入人体内,这种菌每多存在一天,患者的死亡风险就上升2.5倍。
更麻烦的是,多数黏质沙雷菌菌株对包括红霉素、四环素、环丙沙星、哌拉西林和头孢氨苄在内的数种抗生素具有耐药性,感染以后就非常难以治愈。
不过,对于存在在环境中的菌落,还是很好将其清除的。人们可以用稀释过的漂白粉水或含有漂白成分的清洗剂进行擦拭,同时保持环境干燥通风,就可以有效去除这种菌落。
不得不说,今天小编又涨知识了!












































